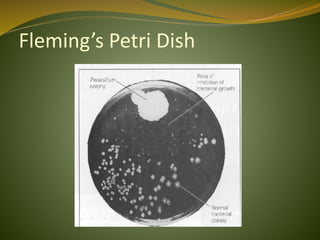
Fleming’s Petri Dish

This document provides an overview of antimicrobials (also known as antibiotics). It defines antimicrobials and discusses their classification as bactericidal or bacteriostatic. The document outlines the history of antimicrobial discovery and discusses their sources, selective toxicity, and modes of action. Key topics covered include the classification of antibiotics based on chemical structure and mechanism of action, as well as details on specific classes of antibiotics like penicillins, cephalosporins, carbapenems, and others.